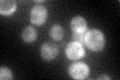
YHR013C
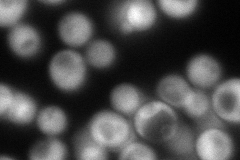
YHR013C
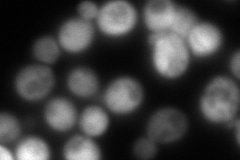
YHR013C
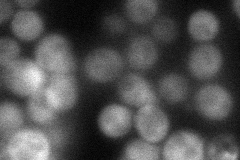
YHR013C
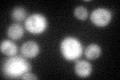
YHR013C
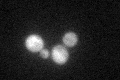
YHR013C
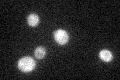
YHR013C

View description
Subunit of N-terminal acetyltransferase NatA (Nat1p, Ard1p, Nat5p); acetylates many proteins and thus affects telomeric silencing, cell cycle, heat-shock resistance, mating, and sporulation; human Ard1p levels are elevated in cancer cells
Localization:
Intensity:
Fold change:
Significance:
-
C’ GFP library in SD
cytosol61.24 -
N' NOP1pr-GFP in SD
cytosol162.692 -
N' TEF2pr-mCherry in SD
cytosol278.107 -
N' NATIVEpr-GFP in SD
cytosol48.9059 -
N' TEF2pr-VC and Cyto-VN in SD

cytosol43.7088 -
C’ GFP library in SD+DTT
cytosol51.380.83No -
C’ GFP library in SD+H2O2
cytosol51.220.83No -
C’ GFP library in Starvation Media
cytosol44.40.72No -
C’ GFP library on the background of Pup2-DaMP

cytosol -
C’ GFP library on the background of CCT mutant

cytosol54.56070.890842No
